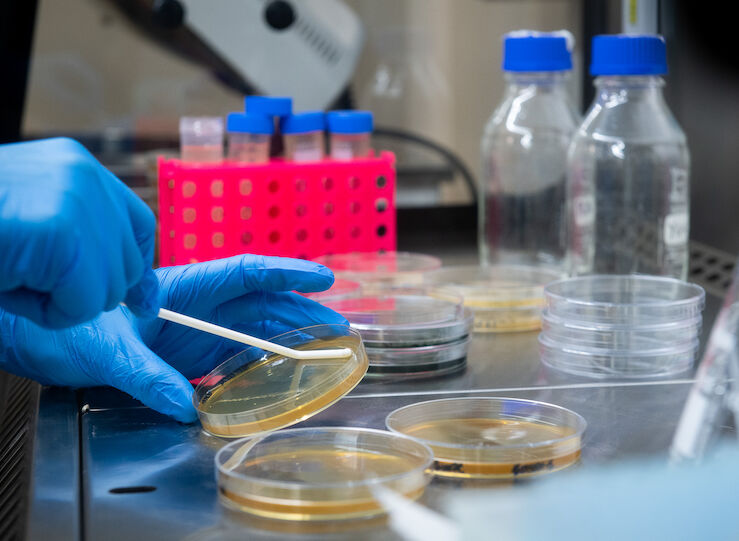

Su mayor virtud es cómo ha conseguido aunar todo el ecosistema de la región, con una red de mentores "muy expertos y cercanos" en el día a día.
Según Reyes Maroto, “van a contribuir a la digitalización de nuestras pymes, mejorando su competitividad y contribuyendo a la generación de empleo".
26 abril 2024
Cazado un profesor de autoescuela cuando circulaba en clase práctica...
26 abril 2024
Vox destaca que los datos son "mejores" que los nacionales porque...
26 abril 2024
Luis Landero y Pablo Vierci llegan a la Feria del Libro de Cáceres
26 abril 2024
"Alarma" en la Creex por la "fuerte caída" de la población...
26 abril 2024
CCOO: "Malos datos" EPA confirman "necesidad" de sumarse a la...